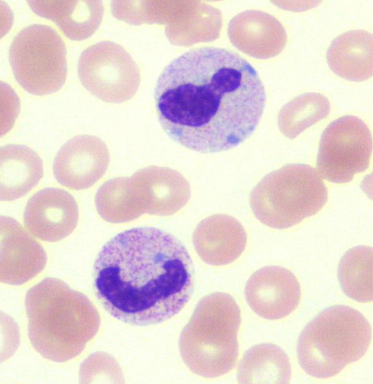

The presence of what can indicate that the anemia is regenerative?
nRBCs accompanied by reticulocytes (appropriate metarubricytosis)
if no reticulocytes, presence of nRBCs = bone marrow or splenic dz
What changes indicate leukocytosis?
- Neutrophilia
- Lymphocytosis
- Monocytosis
- Eosinophilia/Basophilia

What are the acute phase proteins? Which are positive and which are negative?
Acute Phase Proteins
1. Positive = concentrations INCREASE in response to inflammation (fibrinogen)
2. Negative = concentrations DECREASE in response to inflammation (albumin)
Hyperphosphatemia is associated with what function in the kidneys?
Decreased GFR – elevated renal values (BUN, Crea) will support increased P as well.
How to calculate corrrected chloride value
[average Na/measured Na] x measured Cl
average = based on RI of lab you are using
Bilirubin is made by what?
Bilirubin = a byproduct of heme breakdown
- heme breaksdown -> unconjugated Bi
- unconjugated Bi transformed into conjugated by liver
- most conj. Bi reamins in hepatic circulation; small amt. in urine
Exocrine pancreas function
- Acinar cells: secrete digestive enzymes via trypsin that act on CHOs, fats, proteins
- Ductal cells: secrete bicarb to neutralize acidic gastric contents in duodenum
increased lipase, amylase, TLI and PLI indicate what?
increased acinar pancreatic damage; decreased GFR
acinar cells can’t digest CHOs, fats, protein
TLI and PLI decrease with what?
chronic pancreatitis (inappropriate or early activation of digestive enzymes), acinar atrophy
EPI
exocrine pancreatic insufficiency: pancreatic acinar cells fail to secrete digestive enzymes -> chronic weight loss despite ravenous appetite
Cobalamin and folate pattern in EPI
- Cobalamin decreases
- Folate increases

cobalamin absorbed by distal SI and ileum
folate absorbed by proximal SI (duodenum)
Reference Interval calculation
the mean +/- two standard deviations

What are the 3 categories of sources of lab errors?
- Preanalytical (pre-lab arrival) Majority
- Analytical (lab error)
- Postanalytical (mismatch of results to patient delivery)
Preanalytical error
What are the 3 factors of Quality Control/Assurance (QC/QA) for Preanalytical error
- Standard Operating Procedures
- Training of personnel
- Communication with clients
What are the 5 factors of Quality Control/Assurance (QC/QA) for Analytical error
- SOP
- Training of personnel
- Automation
- Monitoring results
- Certification
What are the 4 factors of Quality Control/Assurance (QC/QA) for Postanalytical error
- SOP
- Training of personnel
- Automation
- Communication w/ clients
Cause of artifact hypoglycemia
sample left out too long -> cells in blood consume the glucose
Cause of artifact hypocalcemia/no Ca and hyperkalemia
- incorrect collection tube (K3EDTA)
- EDTA Chelates Ca - K3EDTA tube -> false hyperkalemia due to K3
Cause of artifact high anion gap metabolic acidosis?
high AG, low bicarb
tube left open for too long -> CO2 loss
remember: pH is directly related to bicarb concentration
What are Heinz bodies
damaged hemoglobin
elevated MCH, MCHC, reticulocytes, platelets

artifact changes from EDTA (2)
decreased MCV, decreased HCT
what leukon inclusions can be seen in an old sample?
Döhloe Bodies
How does hemolysis affect HCT/PCV?
decreases it
delayed analysis of urine sample can cause what artifacts?
falsely basic sample, proliferation of microbes (contamination or pathogens), degradation of formed elements like casts or of chemical analytes like ketones and bilirubin


